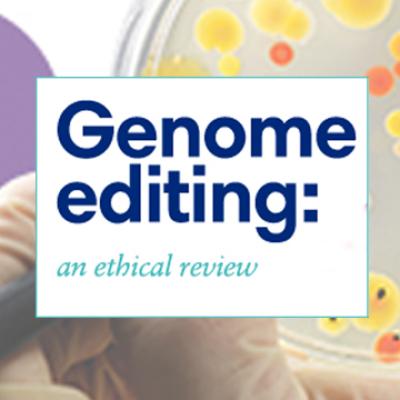

HERRAMIENTAS DIDÁCTICAS PARA CRISPR
RECURSOS EN LÍNEA
Todo lo que necesita saber sobre la edición genética mediante CRISPR (revista WIRED)
#1
#2
What Are Genome Editing and CRISPR-Cas9? (Genetics Home Reference)
CRISPR-Cas9: mecanismo y aplicaciones (el HHMI BioInteractive)
#3
#4
What Is Genome Editing? (National Human Genome Research Institute)
Plan de clases para escuelas sobre la edición genética mediante CRISPR en animales (The New York Times)
#5
#6
Lesson Plan: Genome Editing and CRISPR (Personal Genetics Education Project / PgEd)
En un gran avance, los científicos eliminan una peligrosa mutación de los genes de los embriones humanos (The New York Times)
#7
#8
CRISPR/Cas9: What Is It?, How Does It Work?, What About the Future? (DNA Dots)
La edición fácil del ADN va a rehacer el mundo. Abróchese el cinturón (revista WIRED)
#9
#10
CRISPR in 2018: Coming to a Human Near You (MIT Technology Review)
La edición del genoma en pocas palabras: ¿qué, por qué y cómo? (Consejo de Bioética de Nuffield)
#11
#12
‘Gene Drives’ Are Too Risky for Field Trials, Scientists Say (The New York Times)

Explore recursos genómicos
Nuestra biblioteca de recursos gratuitos cuenta con planes de lecciones, videos, juegos interactivos y otro contenido educativo del Instituto Nacional de Investigación del Genoma Humano y nuestros socios.

Lea Genómica: conocimientos
Lea artículos escritos por investigadores prometedores que comunican actividades científicas que realizan en el laboratorio para informar, educar y crear conciencia sobre la genética y la genómica.